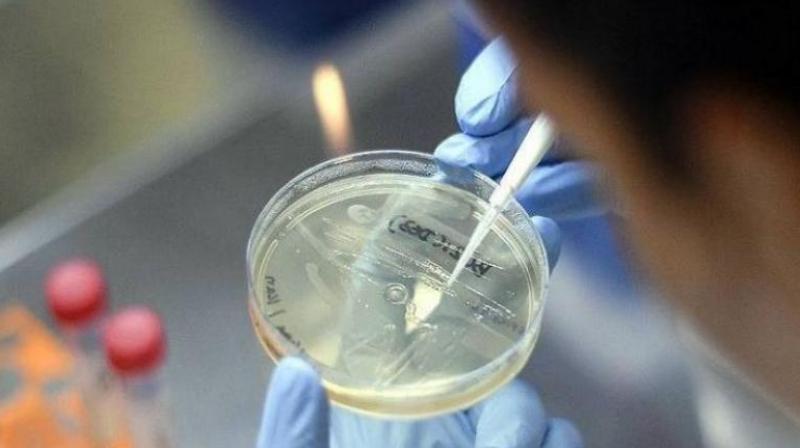

ਭਾਰਤ ਵਿੱਚ, ਨਮੂਨੀਆ ਦੇ ਟੀਕੇ ਦੇ ਉਤਪਾਦਨ ਨੂੰ ਮਨਜ਼ੂਰੀ ਦੇ ਦਿੱਤੀ ਗਈ ਹੈ।
ਭਾਰਤ ਵਿੱਚ, ਨਮੂਨੀਆ ਦੇ ਟੀਕੇ ਦੇ ਉਤਪਾਦਨ ਨੂੰ ਮਨਜ਼ੂਰੀ ਦੇ ਦਿੱਤੀ ਗਈ ਹੈ। ਟਰਾਇਲ ਦੇ ਸਾਰੇ ਪੜਾਅ ਸਫਲ ਹੋਣ ਤੋਂ ਬਾਅਦ, ਡਰੱਗ ਕੰਟਰੋਲਰ ਜਨਰਲ ਆਫ਼ ਇੰਡੀਆ (ਡੀ.ਸੀ.ਜੀ.ਆਈ.) ਨੇ ਮਾਰਕੀਟ ਪ੍ਰਵਾਨਗੀ ਵਿਚ ਟੀਕੇ ਦੀ ਮਾਰਕੀਟਿੰਗ ਕਰਨ ਦੀ ਆਗਿਆ ਦਿੱਤੀ।
pneumonia vaccine
ਪੁਣੇ ਸਥਿਤ ਕੰਪਨੀ ਸੀਰਮ ਇੰਸਟੀਚਿਊਟ ਆਫ ਇੰਡੀਆ ਪ੍ਰਾਈਵੇਟ ਲਿਮਟਿਡ ਦੁਆਰਾ ਪੂਰੀ ਤਰ੍ਹਾਂ ਵਿਕਸਿਤ ਨਿਮੋਕੋਕਲ ਪੌਲੀਸੈਕਰਾਇਡ ਕੰਜੁਗੇਟ ਟੀਕਾ ਬਣਾਈ ਗਈ ਹੈ, ਜੋ ਵਿਸ਼ਵ ਭਰ ਵਿੱਚ ਟੀਕੇ ਦੇ ਉਤਪਾਦਨ ਦੇ ਖੇਤਰ ਵਿੱਚ ਮੋਹਰੀ ਕੰਪਨੀਆਂ ਵਿੱਚ ਗਿਣਿਆ ਜਾਂਦਾ ਹੈ।
pneumonia vaccine
ਸੀਰਮ ਇੰਸਟੀਚਿਊਟ ਨੇ ਭਾਰਤ ਵਿਚ ਇਸ ਨਿਮੋਕੋਕਲ ਪੋਲੀਸੈਕਰਾਇਡ ਕੰਜੁਗੇਟ ਟੀਕੇ ਦੇ ਪਹਿਲੇ, ਦੂਜੇ ਅਤੇ ਤੀਜੇ ਪੜਾਅ ਦੇ ਕਲੀਨਿਕਲ ਟਰਾਇਲ ਕਰਵਾਏ ਹਨ। ਇਹ ਦਾਅਵਾ ਕੀਤਾ ਜਾਂਦਾ ਹੈ ਕਿ ਇਹ ਪਹਿਲਾ ਮੌਕਾ ਹੈ ਜਦੋਂ ਦੇਸ਼ ਦੇ ਅੰਦਰ ਸਾਰੇ ਟਰਾਇਲ ਪੂਰੇ ਹੋਏ ਹਨ। ਹਾਲਾਂਕਿ, ਗੈਂਬੀਆ ਅਤੇ ਹੋਰ ਦੇਸ਼ਾਂ ਵਿੱਚ, ਕੰਪਨੀ ਪਹਿਲਾਂ ਹੀ ਇਸ ਟੀਕੇ ਦੀ ਕੋਸ਼ਿਸ਼ ਕਰ ਚੁੱਕੀ ਹੈ।
pneumonia vaccine
ਸਾਰੇ ਪੜਾਵਾਂ 'ਤੇ ਕਲੀਨਿਕਲ ਟਰਾਇਲ ਕਰਨ ਤੋਂ ਬਾਅਦ, ਕੰਪਨੀ ਨੇ ਇਸ ਟੀਕੇ ਦੇ ਨਿਰਮਾਣ ਅਤੇ ਵਪਾਰ ਦੀ ਆਗਿਆ ਲਈ ਅਰਜ਼ੀ ਦਿੱਤੀ। ਇਸ ਟੀਕੇ ਲਈ ਬਣਾਈ ਗਈ ਵਿਸ਼ੇਸ਼ ਮਾਹਰ ਕਮੇਟੀ (ਐਸਈਸੀ) ਦੀ ਸਹਾਇਤਾ ਨਾਲ, ਡੀਜੀਸੀਆਈ ਨੇ ਟਰਾਇਲ ਦੇ ਸਾਰੇ ਪੜਾਵਾਂ ਦੇ ਨਤੀਜਿਆਂ ਅਤੇ ਅੰਕੜਿਆਂ ਦੀ ਸਮੀਖਿਆ ਕੀਤੀ ਅਤੇ ਉਤਪਾਦਨ ਅਤੇ ਮਾਰਕੀਟਿੰਗ ਦੀ ਮਨਜ਼ੂਰੀ ਲਈ ਸਿਫਾਰਸ਼ ਕੀਤੀ।
Vaccine
ਸਿਹਤ ਅਤੇ ਪਰਿਵਾਰ ਭਲਾਈ ਮੰਤਰਾਲੇ ਦੀ ਇਕ ਰੀਲੀਜ਼ ਦੇ ਅਨੁਸਾਰ, ਨਮੂਨੀਆ ਦੇ ਖੇਤਰ ਵਿਚ ਇਹ ਪਹਿਲੀ ਸਵਦੇਸ਼ੀ ਵਿਕਸਿਤ ਟੀਕਾ ਹੈ। ਪਹਿਲਾਂ, ਅਜਿਹੇ ਟੀਕਿਆਂ ਦੀ ਮੰਗ ਨੂੰ ਵੱਡੇ ਪੱਧਰ 'ਤੇ ਪੂਰਾ ਕੀਤਾ ਜਾਂਦਾ ਸੀ, ਪਰ ਸਿਰਫ ਵਿਦੇਸ਼ੀ ਕੰਪਨੀਆਂ ਹੀ ਟੀਕਾ ਲਗਾਉਂਦੀਆਂ ਸਨ। ਇਹ ਲਾਇਸੰਸਸ਼ੁਦਾ ਕੰਪਨੀ ਦੁਆਰਾ ਦੇਸ਼ ਵਿਚ ਪਹਿਲੀ ਵਾਰ ਹੈ।
ਇਸ ਟੀਕੇ ਦੀ ਵਰਤੋਂ ਬੱਚਿਆਂ ਵਿੱਚ ‘ਸਟ੍ਰੈਪਟੋਕੋਕਸ ਨਮੂਨੀਆ’ ਕਾਰਨ ਹੋਣ ਵਾਲੇ ਹਮਲੇ ਵਾਲੀ ਬਿਮਾਰੀ ਨਮੂਨੀਆ ਵਿਰੁੱਧ ਕਿਰਿਆਸ਼ੀਲ ਟੀਕਾਕਰਨ ਲਈ ਕੀਤੀ ਜਾਂਦੀ ਹੈ। ਇਹ ਜਾਣਿਆ ਜਾਂਦਾ ਹੈ ਕਿ ਇੱਥੇ ਨਮੂਨੀਆ ਦੀਆਂ ਵੱਖ ਵੱਖ ਕਿਸਮਾਂ ਹਨ, ਜਿਵੇਂ ਕਿ ਬੈਕਟਰੀਆ ਨਮੂਨੀਆ, ਵਾਇਰਲ ਨਮੂਨੀਆ, ਫੰਗਲ ਨਮੂਨੀਆ, ਆਦਿ। ਸਟ੍ਰੈਪਟੋਕੋਕਸ ਨਮੂਨੀਆ ਸਭ ਤੋਂ ਆਮ ਬੈਕਟੀਰੀਆ ਹੈ ਜੋ ਫੇਫੜੇ ਦੀ ਸੋਜਸ਼ ਦਾ ਕਾਰਨ ਬਣਦਾ ਹੈ।
Punjabi News ਨਾਲ ਜੁੜੀ ਹੋਰ ਅਪਡੇਟ ਲਗਾਤਾਰ ਹਾਸਲ ਕਰਨ ਲਈ ਸਾਨੂੰ Facebook ਤੇ ਲਾਈਕ Twitter ਤੇ follow ਕਰੋ